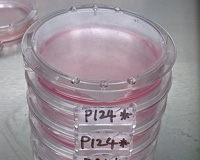
三博特 SHellDisH贝壳型培养皿-培养皿

三博特 SHellDisH贝壳型培养皿(200个/箱、10个/包)一按即开,具有可注释功能,可在培养皿边写下注释,方便区分培养皿,不会弄错。可上锁,防止移动时培养皿底脱落。不易受污染。
一按即开
用一根手指就可开盖,更效率并且减低培养皿被污染的可能。同时培养皿盖可保持倾斜打开状态。

注释功能
可在培养皿边写下注释,方便区分培养皿,不会弄错。
上锁功能
旋转就可上锁及解锁。上锁后可防止移动时培养皿底脱落。

不易受污染
经特别设计,手指不容易碰到培养皿边缘,无须担心培养皿被污染。
一根手指即可锁上/ 打开培养皿,锁上培养皿后,盖子和培养皿不会分开,移动时培养皿不会跌落。
培养皿旁边有专门写标签的地方,不必担心拿错盖子。
把盖子边缘嵌入标签部便可让盖子保持倾斜打开状态。
培养皿的形状使手指难以碰到培养皿和盖子的边缘,无需担心污染可放心使用。
经镜面处理,极为透明,方便放在显微镜上观察。
即使上锁,盖子和培养皿间仍留有空隙,方便气体交换。
| 产品编号 | 产品规格 |
| 26000 | 200个/箱 |
| 26001 | 10个/包 |
产品仅限用于研究,请勿用于治疗等其他用途。
